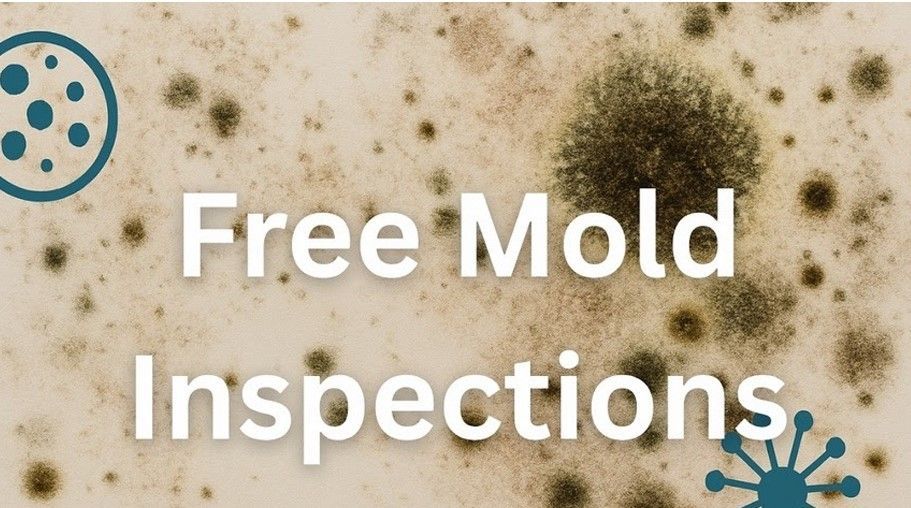

Certified Mold Removal Services
If you suspect there’s mold festering in your property and need mold removal and repair services – whether you found the mold growing in your basement, attic, or crawl space – Our expert mold cleanup and removal technicians can take care of it all. We provide the only in-depth mold cleanup and removal services you need to get the job done right the first time, and to get your home happy and healthy again.

Making Your Home Clean and Healthy Again
It can be very alarming when you find mold in your home or business. Unless it’s safely and properly removed it can put your health, and the value of your property, at risk.
The number one priority is to make sure that mold never even has the chance to grow. Having our restoration experts take care of any water loss incident is the best way to ensure that your residential or commercial property is completely dried out. This greatly reduces the chance of mold growing and thriving in your home or business.
Experienced in Safe Mold Removal Techniques
Mold is harmful to both your health and your home or business. It can cause severe damage to the structural integrity of a building, while also posing a serious risk to the health of those who live or work in that building.
Mold spores can cause respiratory issues and trigger allergy-type symptoms such as red, watery eyes, stuffy nose, headaches, and coughing. Our professional mold removal technicians are trained and certified in the methods of the Institute for Inspection, Cleaning, and Restoration Certification (IICRC) and have many years of mold cleanup and removal experience under their belts.
Our mold cleanup and removal process:
➤ Flood Clean-up & Water Removal
➤ Complete Dry Out
➤ Mold Eradication
➤ Sanitation
➤ Restoration